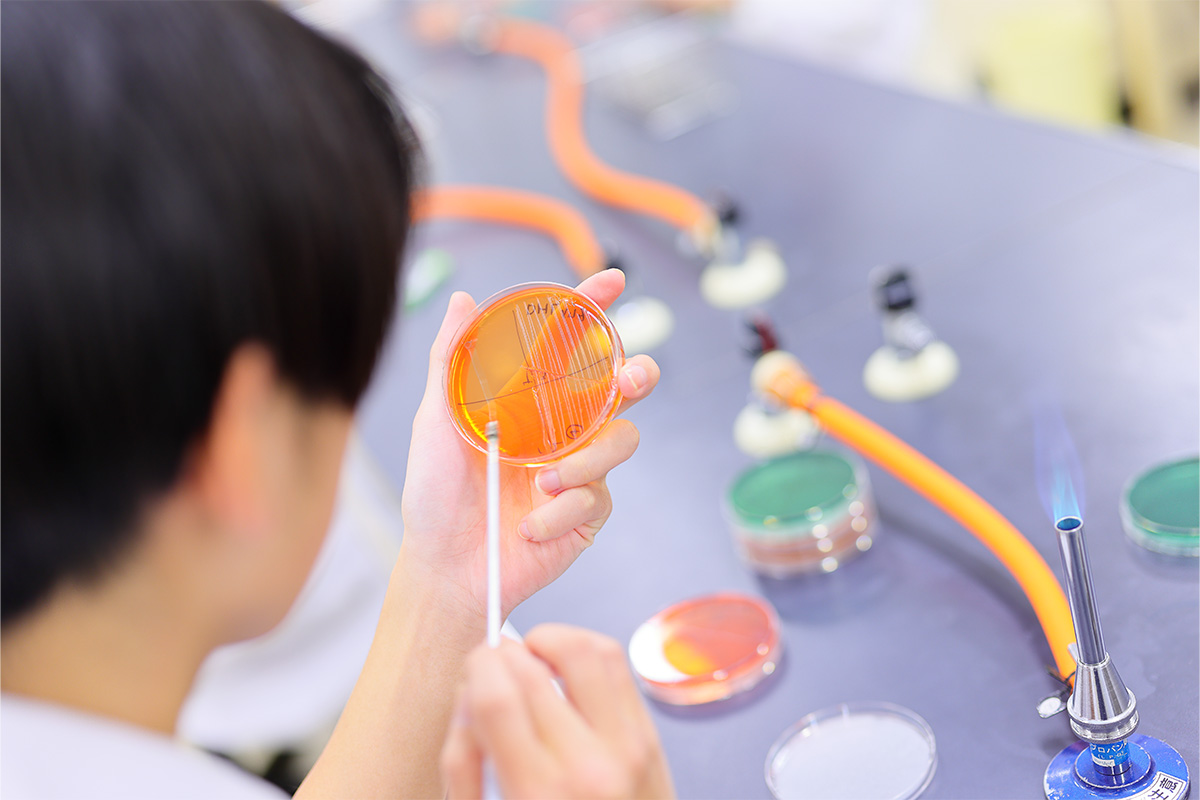

医療・医療技術系バイオ技術者
こんな仕事です:
- 医療・薬品をはじめ、幅広いフィールドで活躍する専門知識とスキルを持つ技術者。
- 遺伝子組換え、細胞融合、細胞培養などの技術で革新をもたらすバイオテクノロジー。医薬、創薬の分野はもちろん、「テーラーメイド医療」や「再生医療」といった高度医療の分野でも、バイオ技術者が活躍しています。
目指せる!指導・サポート
3つのポイント!
- ベーシックな知識や技術の習得が不可欠なバイオテクノロジー。きめ細かい指導で最先端の技術を持ったプロフェッショナルを育成!
- 毒物劇物取扱者、危険物取扱者、登録販売者などの関連する国家資格、実験動物技術者やバイオ技術者などの認定資格など、様々な資格の取得を目指す!
- 細胞や微生物、実験動物の取扱い技術などを習得し、卒業後は医薬・医療分野などで専門技術者として活躍!
目指せる教育教育内容をもっと詳しく

実験対象生物や実験機器の取扱いなど基礎技術を学びながら、資格取得も同時進行。
バイオテクノロジーの基礎技術を入学直後からしっかりと学びます。対策授業を履修した上で、入学から数か月後には国家資格である「毒物劇物取扱者」に全員がチャレンジします。

入学直後から卒業後の進路を見すえた対策を開始。手厚いキャリア支援でサポート。
希望就職先のアドバイスやSPI試験対策など、1年次より国家資格キャリアコンサルタントを持つ専任職員と担当教員が就職指導を行います。また、企業関係者を招いてのガイダンスも行っています。
バイオテクノロジーを学ぶ専門的な実習と、資格試験対策や就職活動をサポート。
細胞培養、免疫化学、食品衛生、微生物発酵、高度な動物実験などレベルの高い実習を数多くこなし、技術を確実に身につけます。同時に「中級バイオ技術者」認定試験対策を徹底し、「実験動物2級技術者」「登録販売者」などの資格取得についてもサポートします。
バイオ技術者を
目指せる学校は
掲載している情報は、
掲載校より寄せられた内容に基づいております。
掲載校より寄せられた内容に基づいております。